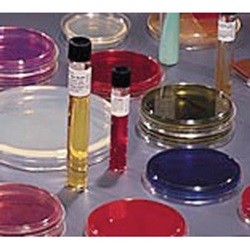

This is an alert about new products, services, trainings, jobs, weather, sales, holidays, closings, etc. New products
Mycoflask™ TSI Agar™ Slant Tube with Tight Cap
TSI Agar™ Slant Tube, 4 to 5 ml, Beige, Liquid Format, 2 to 8°C Storage Temperature, 365 Days Shelf Life, Sterile, Disposable, Ready-to-use, with Tight Cap, Cultivation of Fastidious and Non-fastidious Microorganisms
- Manufacturer Part No: 221038
- SECO Part No: 221038
- Sold As:
-
Availability:

Login to View Your Price
-
List Price :

BD Mycoflask™ sterile, disposable and ready-to-use BD BBL™ culture media are prepared in the special BD Mycoflask. This variety of media helps isolate and cultivate tubercle bacilli and fungi.
| Packaging Type | : | Size K Tubes with Tight Cap |
| For Use With Application | : | Cultivation of Fastidious and Non-fastidious Microorganisms from Variety of Clinical and Nonclinical Specimens |
| Storage | : | 2 to 8°C |
| Shelf Life | : | 365 Days |
- Approved by CE, AOAC, BAM, BS12, CCAM, CMPH2, COMPF, EP, ISO, MCM9, SMD, SMWW, USDA